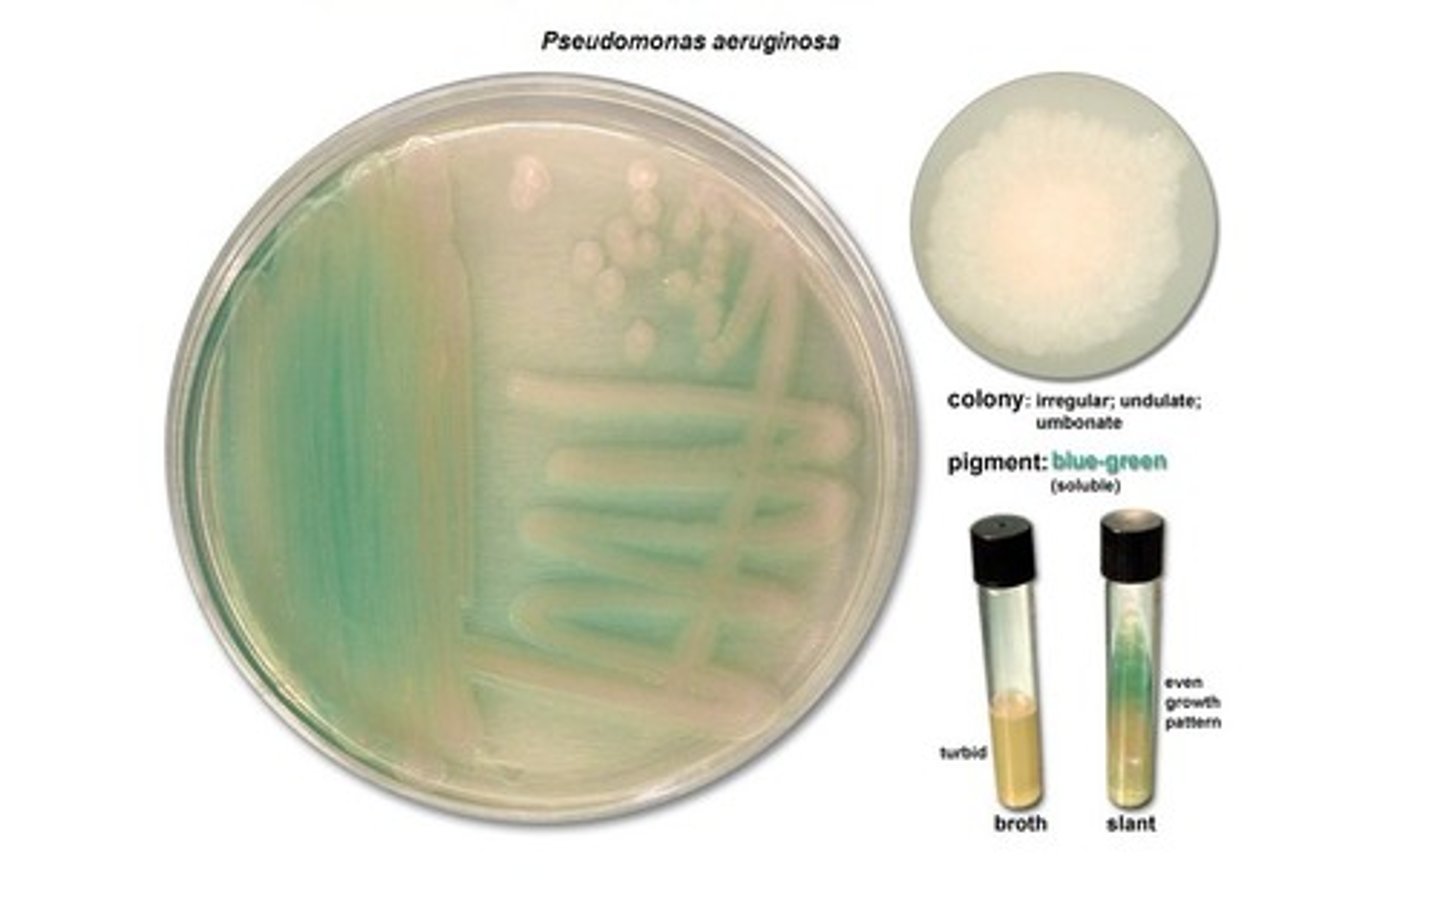
<p>No, you cannot because P. aeruginosa is a Gram negative bacterium which has outer membranes</p><p>Natural penicillins cannot penetrate the outer membranes of Gram negative bacteria</p>
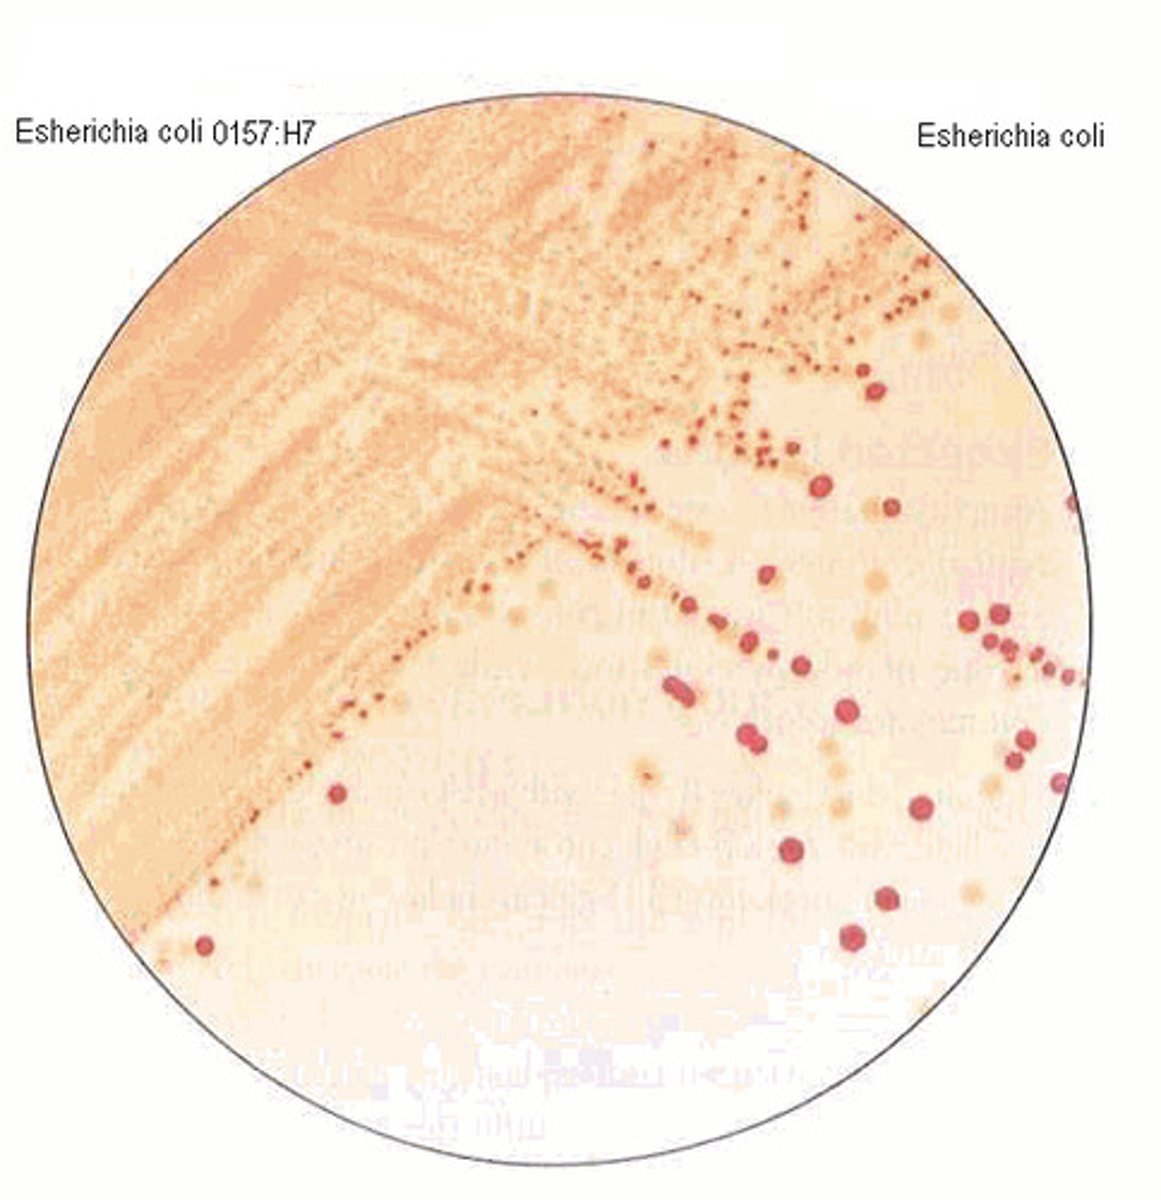
<p>Sorbitol-negative E. coli are serotyped to detect the somatic 157 and flagellar 56 antigens</p>

1/71
Looks like no tags are added yet.
Name | Mastery | Learn | Test | Matching | Spaced | Call with Kai |
|---|
No analytics yet
Send a link to your students to track their progress
Why soap, hand sanitizer, or polymyxin B won't damage your skin cells?
Because you have a layer of dead skin cells and keratin that will not be impacted by any of these microbes

How do salts, lysozyme and antimicrobial peptides inhibit bacteria?
The bacteria does not like the molarity of the salt
These compounds often disrupt the cell wall or membrane integrity

Remember mannitol-salt agar for selecting & differentiating S. aureus
Staphylococcus aureus has enzymes to ferment mannitol and produce acid

How do MRSA strains become resistant to penicillin-like antibiotics?
Remember that penicillin-like antibiotics inhibit by binding to Penicillin-binding Proteins (PBP), an enzyme for catalyzing linkages among amino peptides in peptidoglycans
MRSA strains have a gene called "mecA"
What does mecA do?
mecA encodes a different PBP called PBP2a
Penicillin-like antibiotics, including methicillin, cannot bind
to PBP2a. Therefore, these antibiotics cannot inhibit peptidoglycan synthesis in the MRSA strain

What antibiotics do you not use?
penicillin, amoxicillin, cephalosporins (1-4th generation)

What antibiotics should you use?
vancomycin; sulfonamides; doxycycline, Ceftaroline (5th generation; also binds to PBP2a)

What is the mode of action for vancomycin?
caps the terminus of NAM/NAG peptides → block crosslinking of peptidoglycans

What is the mode of action for sulfonamides?
Inhibit the folic acid (folate; Vitamin B9) synthesis needed for nucleic acid and protein synthesis

What is the mode of action for doxycycline?
Bind to the 30S ribosomal subunit
Tissue/membrane penetration ability

What is the mode of action for Ceftaroline?
treating Methicillin-Resistant Staphylococcus aureus (MRSA)

What is the function of Streptolysins?
hemolysins produced by streptococci; lyse RBCs

What is the function of M proteins?
resists phagocytosis
promote colonization on host mucus
immune system avoidance by preventing phagocytosis

What is the function of Hyaluronidase?
digests polysaccharides (ex: hyaluronic acids) that hold cells together; promote tissue penetration

What is the function of Streptokinase?
activate proteinases to digest and lyse fibrins; resolve blood clots
dissolve blood clots

Streptococcus pyogenes is a Gram-positive bacterium. Good News: S. pyogenes has not developed much of antibiotic resistance. Can you use cephalosporin?
Yes, because it is gram-positive and it has a very thick peptidoglycan layer

Streptococcus pyogenes is a Gram-positive bacterium. Good News: S. pyogenes has not developed much of antibiotic resistance. Can you use natural penicillins (ex: penicillin G)?
Yes, it can be used to treat gram-positive bacteria

Streptococcus pyogenes is a Gram-positive bacterium. Good News: S. pyogenes has not developed much of antibiotic resistance. Can you use isoniazid (INH)?
No, because isoniazid targets mycolic acid which S. pyogenes doesn't have

Can I use natural penicillin (ex: penicillin G or V) to treat burn patients with Pseudomonas aeruginosa infection?
No, you cannot because P. aeruginosa is a Gram negative bacterium which has outer membranes
Natural penicillins cannot penetrate the outer membranes of Gram negative bacteria
Given the answer to the last question, what options do I have?
Gentamicin, Cephalosporin, and Ciprofloxacin

What kinds of vaccines are there?
1. Live attenuated vaccines
2. Inactivated killed vaccines
3. Subunit vaccines
4. Toxoids
5. Recombinant vector vaccines
6. Nucleic acid (DNA) vaccines
7. mRNA vaccines
8. Polysaccharide vaccines
9. Conjugated vaccines

What are polysaccharide vaccines?
made from molecules in pathogen’s capsule; not very immunogenic

What are conjugated vaccines?
used for diseases in children with poor immune response to capsular polysaccharides

What does "virus becomes latent" mean?
it enters a dormant, inactive state within the host's body, where it persists without causing active symptoms or significant replication

Why are shingles limited to one side of the body (for most cases)? Severe cases might have spread to both sides.
Our peripheral neurons are separated (left side or right side). But if your immunity is really low, shingles might spread to both sides

Why Acycylovir can be prescribed to treat patients with shingles?
Because varicella zoster virus (human herpes virus 3) is in the Herpes virus family, HHV3 also has the viral thymidine kinase and the viral DNA polymerase that are drug targets of Acycylovir

Are chickenpox vaccine and shingle vaccine the same?
Yes they are because they're caused by the same virus

We have vaccines for chickenpox or shingles that are caused by Human herpes virus-3. Can we use those vaccines for Herpes simplex viruses (HSV)?
Although Herpes simplex viruses and HHV3 are in the same herpes family, the chickenpox/shingle vaccines CANNOT prevent HSV infection.
However, acyclovir works against all these herpes viruses.
CDC recommends vaccination for children with MMR vaccine (Measles, Mumps, Rubella) to prevent these three diseases. But why is the MMR vaccine NOT recommended for pregnant women?
Infection during pregnacy results in maternal and fetal adverse outcomes, and the vaccine is a live attenuated vaccine

How do miconazole and clotrimazole work to inhibit fungi?
They target the cell walls in fungal cell membranes

How does Nystatin work?
most commonly used for treating Candida albicans infection by inhibiting fungal growth

Eye drops with ciprofloxacin (targets: ) can be prescribed to treat conjunctivitis caused by bacteria. Can you use this antibiotic to treat conjunctivitis caused by adenovirus?
No you can't

What is the drug target of tetracycline?
Binds to 30S subunit of bacterial ribosome to inhibit protein synthesis
Why tetracycline is recommended for treating conjunctivitis caused by Chlamydia trachomatis?
Tetracycline-like antibiotics can penetrate tissues and host cell membranes

Can you use acyclovir or antibiotics to treat Acanthamoeba keratitis?
Not founded in recorded lectures
What type of vaccine is the MenB vaccine (BEXSERO)? What is aluminum
hydroxide for?
It is a protein subunit vaccine
The aluminum hydroxide is used as an adjuvant to increase antibody production

Why do doctors not recommend sushi (raw fish) or unpasteurized dairy food for pregnant women even these food are stored at low temperature?
Because L. monocytogenes can survive and replicate at low temperature
Which staining method you can use to identify Mycobacterium leprae in patient samples?
acid-fast stain

Why is botulism commonly associated with canned food?
The bacteria in the canned food can form endospores to survive under harsh conditions, which may cause them to survive even after heating the food up
Isn't honey very condensed in sugar (a condition with very low water)?
Honey would be a "hypertonic" environment for microbes, where water leaves the microbes and and causes plasmolysis. How come C. botulinum survives in honey?
C. botulinum, a Gram positive bacterium, can form endospores that are resistant to environmental stresses, such as heat, UV, chemicals and hypertonic environments

Why do we need to use RT-PCR to detect Zika virus in patient samples?
Zika virus has single strand (+) RNA genome. The RNA genome needs to be reverse transcribed into DNA as templates for PCR

If the TORCH test shows positive. What does that mean?
It means the patient has been exposed or infected with the test pathogens. Thus, the patient produces IgM against the pathogens. IgM is the first antibody produced during
infection

Although amoebic meningoencephalitis is very rare, the death rate is very high, and we do NOT have many drugs for the disease. Why?
The eukaryotic cell does not have a cell wall so you can't treat it with antibiotics

Is the strep throat test detecting presence of antigens from S. pyogenes or patient’s antibodies against S. pyogenes?
presence of antigens from S. pyogenes

Why amoxicillin can be used for treating ear infection caused by either Gram positive or Gram negative?
Amoxicillin is a broad spectrum antibiotic and is more realistic to use as doctors can pinpoint the exact properties of the bacteria

Can natural penicillin be prescribed for Gram positive caused ear infection?
Yes, but it is rarely the first choice
Can you use amoxicillin to treat ear infection by RSV?
No, you can't use antibiotics to treat viral infections
Why low vaccination (DTaP vaccine) rate contribute to increase of pertussis cases in infants?
First DTaP vaccine shot recommended and approved for infants at 2 months old. From birth to 2 months, infants are vulnerable to pertussis.

Why does TdaP vaccination for pregnant women, adults, and older children help with reducing pertussis in infants?
• Placental transmission of antibodies to the fetus
• Herd immunity!
What is macrolides/erythromycin vaccine?
Erythromycin for treating eye infection and pneumonia
Can you use cephalosporins, penicillin or vancomycin to treat mycoplasma pneumonia?
No. These antibiotics inhibit synthesis of bacterial cell wall
which Mycoplasma pneumoniae doesn't have
Why tetracycline and doxycycline are good drug options for treating C. pneumoniae infection?
They can penetrate cell membranes
What is humanized antibody? What is passive immunity? Is Palivizmab neutralizing RSV?
What type of vaccines are the newly approved RSV vaccines?
Recombinant protein subunits
What does H1 mean? What does N1 mean?
They are unique types of Hemagglutinin and Neuraminidase presenting on the protein structure
We use different serotypes of neuramid and hemagglutinin to identify different influenza viruses
Why do patients with septic shock have decreased blood pressure?
Inflammation triggered by cytokines increases permeability of the blood vessels to let immune cells go the the infection sites. However, fluid in the blood will also pass the epithelium of the blood vessels (this is why swelling occurs). But when the reaction is too much during septic shock, the
patient loses too much fluid and has decreased blood
pressure.
Our immune cells detect LPS (endotoxin) by protein receptors on the cell surface and activate production of immune messengers, cytokines. However, too much LPS causes septic shock in patients because too much cytokines are produced (aka: cytokine storm), which leads to overreactive inflammation. How would you neutralize LPS or cytokines in patients with septic shock to prevent their own immune systems from overreacting and killing themselves?
Couldn't find answer by listening to lecture
Given the previous question, can Humira (anti-TNFalpha antibody) work?
No, it can actually increase your risk of attaining an infection

Which bacterium is one of ESKAPE?
Enterococcus faecium

Lethal toxin and edema toxin are proteins with enzyme activities to disrupt host cell functions. Are they the A subunits or B subunits? Is protective antigen an A subunit or B subunit?
The lethal and edema toxins are B subunits
The protective antigen is the A subunit

Direct sandwich ELISA detects?
Antigens of B. burgdorferi

Indirect fluorescent-antibody test detects?
Human antibodies against B. burgdorferi

Indirect Western blot detects?
Human antibodies against B. burgdorferi

What are the advantages of tetracycline and chloramphenicol?
The ability to penetrate tissue and human cell membranes

Why taking penicillin antibiotics (or other antibiotics) is NOT recommended for treating infectious mononucleosis?
Because it is a viral infection and they won't work

Vesicular stomatitis virus primarily infects horses, cattle, and swine but only cause flu-like symptoms in humans. Can you think of an example of live recombinant viral vector vaccine?
ERVEBO Ebola Zaire vaccine

Can you use antibiotics (ex: chloramphenicol or tetracycline) to treat patients with malaria or toxoplasmosis?
No, they attack different things

E. coli O157:H7 serotyping
Sorbitol-negative E. coli are serotyped to detect the somatic 157 and flagellar 56 antigens
How does vancomycin work?
Inhibits peptidoglycan crosslinking

What is the drug target of fidaxomicin?
Fidaxomicin inhibits C. difficile

Do human cells use reverse transcriptase?
No
Can you think of another drug targeting viral reverse transcriptase?
AZT targets HIV reverse transcriptase
